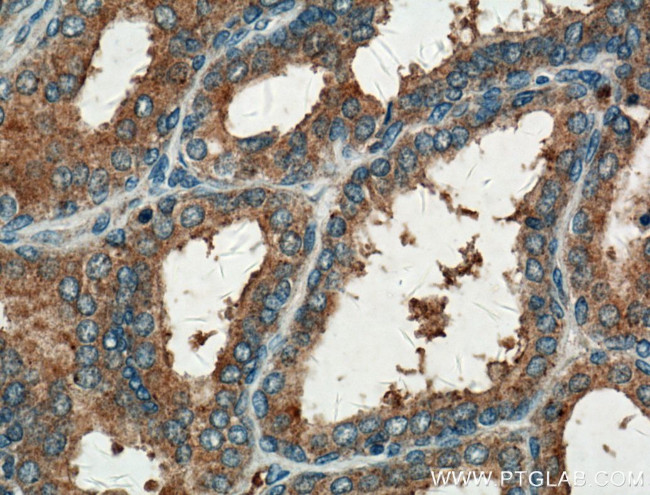
GNMT Antibody in Immunohistochemistry (Paraffin) (IHC (P))

Search
Proteintech
GNMT Polyclonal Antibody
{{$productOrderCtrl.translations['antibody.pdp.commerceCard.promotion.promotions']}}
{{$productOrderCtrl.translations['antibody.pdp.commerceCard.promotion.viewpromo']}}
{{$productOrderCtrl.translations['antibody.pdp.commerceCard.promotion.promocode']}}: {{promo.promoCode}} {{promo.promoTitle}} {{promo.promoDescription}}. {{$productOrderCtrl.translations['antibody.pdp.commerceCard.promotion.learnmore']}}
产品信息
18790-1-AP
种属反应
已发表种属
宿主/亚型
分类
类型
抗原
偶联物
形式
浓度
规格
纯化类型
保存液
内含物
保存条件
运输条件
产品详细信息
Immunogen sequence: MVDSVYRTR SLGVAAEGLP DQYADGEAAR VWQLYIGDTR SRTAEYKAWL LGLLRQHGCQ RVLDVACGTG VDSIMLVEEG FSVTSVDASD KMLKYALKER WNRRHEPAFD KWVIEEANWM TLDKDVPQSA EGGFDAVICL GNSFAHLPDC KGDQSEHRLA LKNIASMVRA GGLLVIDHRN YDHILSTGCA PPGKNIYYKS DLTKDVTTSV LIVNNKAHMV TLDYTVQVPG AGQDGSPGLS KFRLSYYPHC LASFTELLQA AFGGKCQHSV LGDFKPYKPG QTYIPCYFIH VLKRTD (1-295 aa encoded by B C032627)
靶标信息
The protein encoded by this gene is an enzyme that catalyzes the conversion of S-adenosyl-L-methionine to S-adenosyl-L-homocysteine and sarcosine. The encoded protein is found in the cytoplasm and acts as a homotetramer. Defects in this gene are a cause of GNMT deficiency.
仅用于科研。不用于诊断过程。未经明确授权不得转售。
生物信息学
蛋白别名: 2.1.1.20; epididymis secretory sperm binding protein Li 182mP; Folate-binding protein; glycine methyltransferase; glycine N methyl transferase; Glycine N-methyltransferase
基因别名: Fbp-cII; GNMT; HEL-S-182mP
UniProt ID: (Human) Q14749, (Mouse) Q9QXF8, (Rat) P13255
Entrez Gene ID: (Human) 27232, (Mouse) 14711, (Rat) 25134